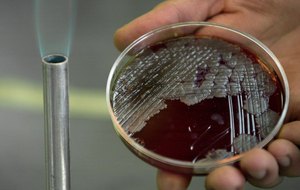

Internacional

27/12/2024 21:56 | ESTADOS UNIDOS
Trump pede à Suprema Corte dos EUA suspensão de lei que proíbe TikTok a partir de 2025

27/12/2024 20:08 | PRESENÇA MILITAR
Senegal fechará todas as bases militares estrangeiras em seu território, diz primeiro-ministro

27/12/2024 18:12 | GÁS NATURAL
Eslováquia considera represália contra Ucrânia devido à situação envolvendo o gás russo

27/12/2024 18:07 | AFASTAMENTO
Coreia do Sul tem segundo impeachment em menos de duas semanas

27/12/2024 16:34 | CAZAQUISTÃO
Azerbaijan Airlines diz que acidente fatal foi causado por 'interferência externa'
27/12/2024 16:16 | RÚSSIA
Mirando nos russos e livrando os americanos: quais armas biológicas o Pentágono está desenvolvendo?

27/12/2024 14:35 | RETROSPECTIVA INTERNACIONAL
Decolonialismo francês, afastamento do FMI e mais integração: o ano de 2024 na África

27/12/2024 13:42 | GUERRA NO ORIENTE
Israel invade hospital no norte de Gaza

27/12/2024 12:45 | GUERRA
Faixa de Gaza: tropas de Israel queimam hospital após remover à força funcionários e pacientes

27/12/2024 12:35 | FAIXA DE GAZA
Israel provoca Hezbollah para guerra em grande escala, diz especialista libanês
Mais lidas
-
1COMUNICAÇÃO
TV Asa Branca corta contratos e congela novos projetos após disputa judicial com TV Gazeta
-
2CRIME
Duas prisões por crimes de pedofilia chocam Palmeira dos Índios
-
3ARAPIRACA
Prefeitura recupera vias nos bairros Guaribas e Verdes Campos em Arapiraca
-
4DIA INTERNACIONAL DA MULHER
8 de março: policial, mas antes de tudo mulher
-
5MACEIÓ
Rui Palmeira denuncia que aplicação do Banco Master foi feita com consultoria investigada pela PF